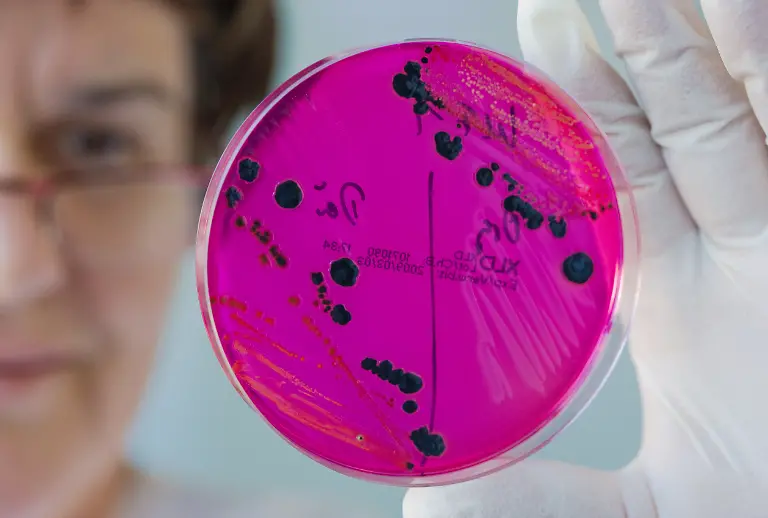
21123634

Bilderserien

Immer derselbe DreckDie ekligsten Lebensmittelskandale
19.02.2013, 09:30 Uhr
Wer billig futtert, darf sich über Gift, Gammel oder Pferd in der Nahrung nicht wundern. Macht ja auch keiner: Schließlich vergeht kaum ein Jahr, ohne dass Dreck im Essen gefunden wird. Vom Glykol-Skandal bis zur Ehec-Krise, ob Salmonellen, Dioxin oder Nitrofen, ob Gammelfleisch oder Gammel-Eier - die Liste der Lebensmittelskandale nimmt kein Ende. Pferd mit Phenylbutazon ist nur das jüngste Kapitel einer Geschichte ohne Ende.